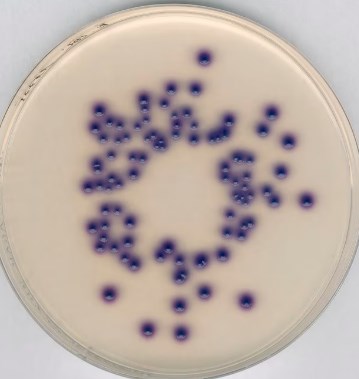

Description
ISO 9308-1: 2014, For the simultaneous detection and enumeration of coliform bacteria and E. coli
Synonyms: Coliform Agar, Chromogenic E. coli Agar, Chromogenic Coliform Agar
General description
Chromocult® Coliform Agar is a granulated, less selective, and differential chromogenic culture medium intended for microbiological analysis of food and water. This medium saves time by enabling the simultaneous detection, differentiation, and enumeration of E. coli and coliforms from drinking water and processed food matrices within 24 hours. This agar is the only chromogenic culture medium which was used for validation to prepare the new ISO 9308-1 (2014) version. The medium contains Tergitol™ 7 as an inhibitor of Gram-positive bacteria without any impact on the growth of the targeted coliforms/ E. coli. Chromocult® Coliform Agar is, therefore, the ideal medium for the detection of coliforms/ E. coli in drinking water and processed foods. It facilitates and speeds up your processes.
Application
Chromocult® Coliform Agar is used for the simultaneous detection of coliform bacteria and E. coli in drinking water, disinfected pool water, finished water from treatment plants and processed food samples.
Analysis Note
Appearance (clearness): slightly turbid to turbid
Appearance (colour): yellowish to yellowish-brown
pH-value (25 °C): 6.6 – 7.0
Growth promotion test in accordance with the current version of DIN EN ISO 11133.
Inoculum on reference medium (Escherichia coli ATCC 25922 (WDCM 00013)):
Inoculum on reference medium (Escherichia coli ATCC 8739 (WDCM 00012)):
Inoculum on reference medium (Enterobacter aerogenes ATCC 13048):
Inoculum on reference medium (Citrobacter freundii ATCC 43864 (WDCM 00006)):
Colony count (Escherichia coli ATCC 25922 (WDCM 00013)):
Colony count (Escherichia coli ATCC 8739 (WDCM 00012)):
Colony count (Enterobacter aerogenes ATCC 13048):
Colony count (Citrobacter freundii ATCC 43864 (WDCM 00006)):
Recovery on test medium (Escherichia coli ATCC 25922 (WDCM 00013)): ≥ 70 %
Recovery on test medium (Escherichia coli ATCC 8739 (WDCM 00012)): ≥ 70 %
Recovery on test medium (Enterobacter aerogenes ATCC 13048): ≥ 70 %
Recovery on test medium (Citrobacter freundii ATCC 43864 (WDCM 00006)): ≥ 70 %
Growth (Enterococcus faecalis ATCC 19433 (WDCM 00009)): partial inhibition
Growth (Pseudomonas aeruginosa ATCC 10145 (WDCM 00024)): no limit
Colonies (Escherichia coli ATCC 25922 (WDCM 00013)): dark-blue to violet
Colonies (Escherichia coli ATCC 8739 (WDCM 00012)): dark-blue to violet
Colonies (Enterobacter aerogenes ATCC 13048 (WDCM 00175)): pink to red
Colonies (Citrobacter freundii ATCC 43864 (WDCM 00006)): pink to red
Colonies (Pseudomonas aeruginosa ATCC 10145 (WDCM 00024)): colourless
Incubation: 21 ± 3 hours at 36 ± 2 °C
A recovery rate of 70 % is equivalent to a productivity value of 0.7.
The indicated colony counts result from the sum of a triple determination.
Reference media: Tryptic Soy Agar
Appearance (colour): yellowish to yellowish-brown
pH-value (25 °C): 6.6 – 7.0
Growth promotion test in accordance with the current version of DIN EN ISO 11133.
Inoculum on reference medium (Escherichia coli ATCC 25922 (WDCM 00013)):
Inoculum on reference medium (Escherichia coli ATCC 8739 (WDCM 00012)):
Inoculum on reference medium (Enterobacter aerogenes ATCC 13048):
Inoculum on reference medium (Citrobacter freundii ATCC 43864 (WDCM 00006)):
Colony count (Escherichia coli ATCC 25922 (WDCM 00013)):
Colony count (Escherichia coli ATCC 8739 (WDCM 00012)):
Colony count (Enterobacter aerogenes ATCC 13048):
Colony count (Citrobacter freundii ATCC 43864 (WDCM 00006)):
Recovery on test medium (Escherichia coli ATCC 25922 (WDCM 00013)): ≥ 70 %
Recovery on test medium (Escherichia coli ATCC 8739 (WDCM 00012)): ≥ 70 %
Recovery on test medium (Enterobacter aerogenes ATCC 13048): ≥ 70 %
Recovery on test medium (Citrobacter freundii ATCC 43864 (WDCM 00006)): ≥ 70 %
Growth (Enterococcus faecalis ATCC 19433 (WDCM 00009)): partial inhibition
Growth (Pseudomonas aeruginosa ATCC 10145 (WDCM 00024)): no limit
Colonies (Escherichia coli ATCC 25922 (WDCM 00013)): dark-blue to violet
Colonies (Escherichia coli ATCC 8739 (WDCM 00012)): dark-blue to violet
Colonies (Enterobacter aerogenes ATCC 13048 (WDCM 00175)): pink to red
Colonies (Citrobacter freundii ATCC 43864 (WDCM 00006)): pink to red
Colonies (Pseudomonas aeruginosa ATCC 10145 (WDCM 00024)): colourless
Incubation: 21 ± 3 hours at 36 ± 2 °C
A recovery rate of 70 % is equivalent to a productivity value of 0.7.
The indicated colony counts result from the sum of a triple determination.
Reference media: Tryptic Soy Agar
PROPERTIES
Agency
AOAC® RI (approved as alternative method for processed foods)
EPA
ISO 9308-1: 2014
Pack Size
500g
sterility
non-sterile
form
granular
manufacturer/tradename
ChromoCult®
technique(s)
microbiological culture: suitable
pH
6.6-7.0 (25 °C, 26.5 g/L in H2O)
solubility
26.5 g/L
application(s)
food and beverages
microbiology
storage temp.
15-25°C
suitability
Escherichia coli
coliforms

Reviews
There are no reviews yet.